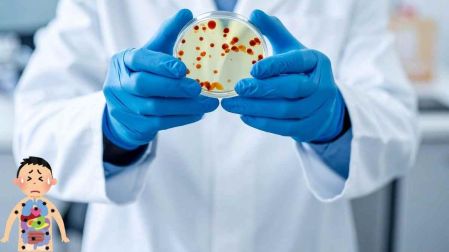
thumb
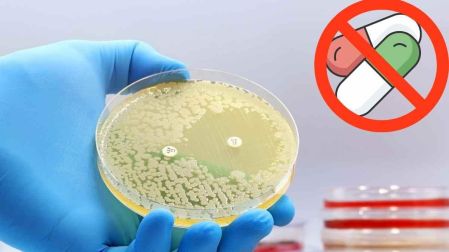
thumb

UNAM desarrolla un sistema para rastrear superbacterias resistentes a antibióticos
La UNAM ha puesto en marcha un sistema de vigilancia genómica que permite rastrear y analizar el ADN de las superbacterias en menos de 30 días

Las superbacterias representan un desafío crítico para el mundo debido a su capacidad para sobrevivir a las medicinas creadas para eliminarlas. Ante este reto, la Universidad Nacional Autónoma de México (UNAM) desarrolla un sistema de vigilancia genómica para monitorear y contener este problema.
Estos microorganismos podrían causar miles de muertes en el futuro, pero la ciencia actual permite rastrearlos y anticipar sus movimientos. El objetivo principal es evitar que infecciones comunes se transformen en pesadillas médicas intratables.

¿Qué son las superbacterias y por qué representan un peligro?
Se trata de tipos de bacterias y hongos que han desarrollado la capacidad de sobrevivir a los fármacos diseñados para exterminarlos. Este fenómeno ocurre por selección natural, un proceso donde los microbios más fuertes logran multiplicarse y heredar su resistencia.
El abuso de medicamentos en humanos y ganado acelera esta evolución, convirtiendo dolencias simples en peligros graves. De acuerdo con los Institutos Nacionales de Salud de EU (NIH), las características que definen a estos enemigos invisibles son:
- Resistencia múltiple: Capacidad de vencer a varios tipos de fármacos de forma simultánea y efectiva.
- Propagación rápida: Facilidad para transmitirse entre personas sanas en cualquier entorno social.
- Evolución genética: Alteración de su ADN para bloquear, expulsar o modificar el medicamento que intenta atacarlos.

¿Cómo funciona el sistema de vigilancia de la UNAM?
El proyecto ViRamSe-CdMx recibe muestras de diversos hospitales de la Ciudad de México para extraer el material genético de los agentes más letales. Mediante el uso de bioinformática, los expertos reconstruyen el genoma para identificar genes de resistencia emergentes.
Este sistema reduce el tiempo de diagnóstico a menos de 30 días, lo que permite que el personal médico actúe con mayor rapidez ante un brote. La operación diaria de este estudio se define a través de los siguientes procesos:
- Recolección clínica: Recepción de muestras peligrosas provenientes de centros de salud estratégicos.
- Análisis del genotipo: Estudio profundo de los genes responsables de la agresividad y evolución del microbio.
- Antibiogramas: Pruebas precisas para elegir el tratamiento ideal para cada paciente analizado.
¿Cuáles son los próximos pasos para el sistema de vigilancia de la UNAM?
La meta final es operar un panel digital que muestre en tiempo real mapas y perfiles de resistencia específicos por zona. Esta información guiará las decisiones de los doctores y la compra inteligente de medicinas que realmente funcionen.
También se vigilan ecosistemas naturales como los cenotes, que sirven como depósitos donde las bacterias intercambian información genética. Los objetivos estratégicos a corto plazo incluyen las siguientes acciones:
- Monitoreo comunitario: Rastrear bacterias resistentes en espacios urbanos y ambientales diversos.
- Detección de brotes: Identificar el origen exacto de infecciones grupales de manera inmediata.
- Guía estratégica: Proveer herramientas digitales para predecir tendencias epidemiológicas y prevenir contagios masivos.
¿Qué hace la ciencia para detener a las superbacterias?
Actualmente, se desarrollan terapias alternativas, como el uso de virus que devoran bacterias y anticuerpos que neutralizan toxinas. Además, se investigan compuestos naturales y nanopartículas que potencian la efectividad de los fármacos actuales.
Así es como la comunidad científica intenta frenar esta amenaza, según explican los NIH y una investigación del Journal of Bio-X Research:
- Anticuerpos monoclonales: Proteínas que neutralizan toxinas y marcan al invasor para que tus defensas naturales lo ataquen.
- Nanotecnología: Uso de partículas microscópicas de plata que transportan la medicina directo al interior del microorganismo.
- Quorum quenching: Técnica para bloquear la comunicación química entre microbios, impidiendo que se coordinen para atacar tus tejidos.
Frenar este peligro requiere responsabilidad individual para que las medicinas sigan salvando vidas en el futuro. Las medidas para interrumpir la cadena de contagio son claras y necesarias para tu bienestar:
- Higiene estricta: Lavado de manos frecuente con jabón para evitar la dispersión de microbios.
- Tratamientos completos: Terminar siempre las dosis recetadas, aunque los síntomas desaparezcan antes de tiempo.
- Cero automedicación: Usar antibióticos solo con receta y jamás para tratar virus como la gripe.
Herramientas como la vigilancia de la UNAM y las acciones preventivas podrían cambiar el rumbo de esta batalla médica. La tecnología y la prevención caminan de la mano para asegurar que cuentes con un futuro más saludable.
EL EDITOR RECOMIENDA



